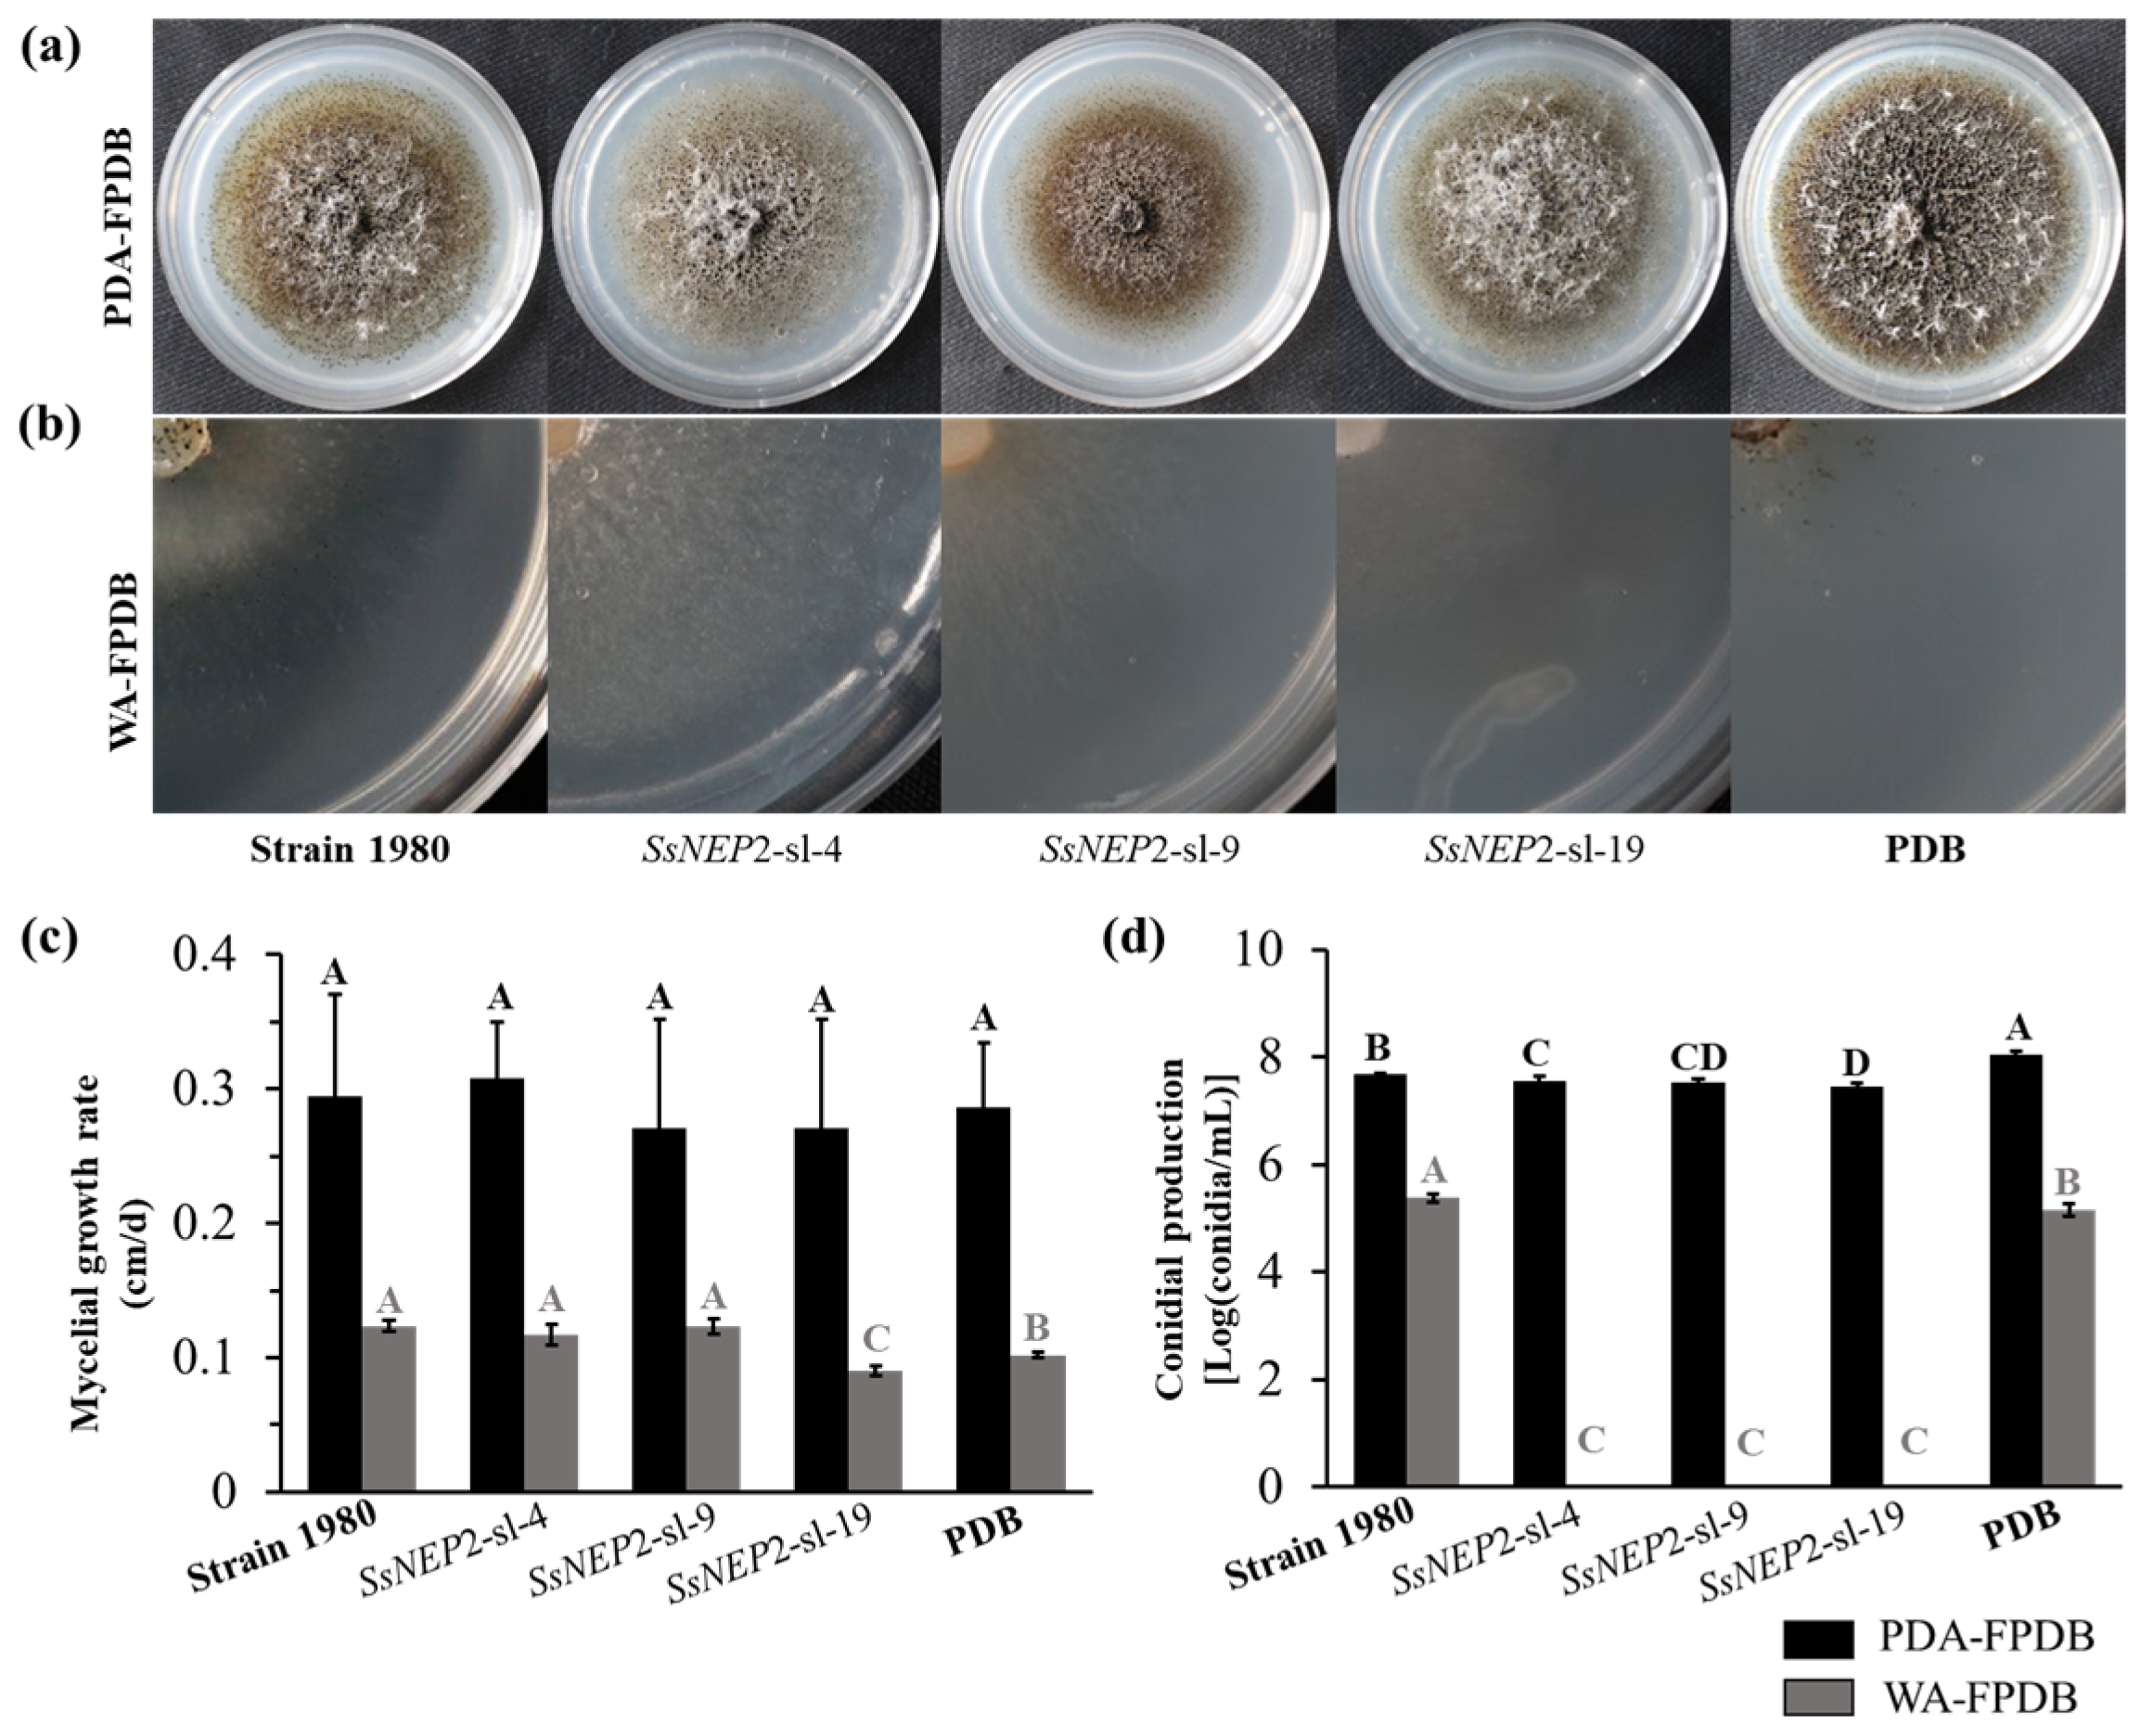
Jof 11 00151 g003 Jof 11 00151 g003

Abstract
Sclerotinia sclerotiorum, a fungal pathogen that is spread worldwide and causes serious diseases on crops, can be parasitized specifically by the mycoparasite Coniothyrium minitans. SsNEP2, encoding a necrosis-inducing protein in S. sclerotiorum, was previously inferred to play a role in the virulence to host plants. In this study, silencing of SsNEP2 in S. sclerotiorum had no significant (p < 0.01) influence on mycelial morphology, while overexpression led to lower mycelial growth and more branches. When amended with the fermentation broth of the SsNEP2 silencing mutants, conidial germination of C. minitans was promoted, while conidial production decreased. When parasitized by C. minitans, enhanced resistance of the SsNEP2 silencing mutants and weaker resistance of the overexpressed transformants were observed compared to the wild-type S. sclerotiorum strain 1980. In addition, the expression of SsNEP2 in C. minitans enhanced mycelial parasitism on S. sclerotiorum and restored the effect of silencing SsNEP2 in S. sclerotiorum on mycoparasitism. Thus, we highlight the role of SsNEP2 as a PAMP-like protein in the mycoparasitism between C. minitans and its host fungus S. sclerotiorum. SsNEP2 can be used to promote the biological potential of C. minitans.
1. Introduction
Sclerotinia sclerotiorum (Lib.) de Bary is a destructive plant pathogen that is found worldwide on many plants and causes Sclerotinia diseases and enormous economic losses each year [1,2,3,4]. Coniothyrium minitans Campbell specifically parasitizes mycelia and sclerotia of S. sclerotiorum and reduces sclerotia inocula in soil. Therefore, it has been developed into a commercial microbial agent to control Sclerotinia diseases [5,6]. Though the mycoparasitic mechanisms between S. sclerotiorum and C. minitans have received much attention, most of the research has focused on C. minitans [7,8,9,10]. The response of the host S. sclerotiorum to parasitism is largely undiscovered [11].
Necrosis- and ethylene-inducing peptide 1 (NEP1) from the culture filtrates of Fusarium oxysporum, a pathogen to Erythroxylum coca, was the first isolated NEP1-like protein (NLP) [12,13]. Since then, NLPs have been identified as ubiquitous in bacteria, oomycetes, and fungi, while no NLP homologs are found in animals, plants, or archaea [14,15,16,17,18,19]. NLP critically contributes to the virulence of fungal pathogens and the spread of diseases. The NLP gene copy number in different species varies. The largest NLP family, encoded by 50-60 loci in each species, was discovered in the Phytophthora species [20]. Neurospora crassa carries a single gene encoding NLP. Magnaporthe oryzae and Gibberella zeae each contain four NLP genes [21]. Two NLP homologs are present in S. sclerotiorum and its closely related genus Botrytis [22,23]. There are also two NLPs predicted in the genome of two Sclerotinia parasitic fungi: Trichoderma harzianum [24] and Clonostachys rosea [25]. All NLPs share a conserved heptapeptide motif “GHRHDWE” and either two or four conserved cysteine residues [26]. Based on the cysteine residues and phylogenetic analysis, NLPs are divided into two types: type I, which contains two cysteine residues, and type II, which has four cysteine residues [16]. Both types are cytotoxic to plant cells, albeit with different mechanisms. While type I NLPs possess a cation-binding pocket, which is required for cytotoxicity, type II NLPs contain a cytotoxicity-associated calcium-binding motif [17].
Up-regulation of NLP is an important phenomenon in pathogens during the infection process [27,28]. In M. oryzae, all four MoNLPs were found to be significantly up-regulated during the infection of rice plants, and the quadruple ΔMoNLP mutants showed similar virulence, sporulation, and radial growth under various unfavorable cultural conditions to the wild-type strain P131, indicating that the Nep1-like protein family is dispensable for infection to rice plants and itself [21]. Both VdNLP1 and VdNLP2 (both belonging to type I) of Verticillium dahliae were highly induced at the late stage of infection of Solanum lycopersicum leaves, while deletion of them had no significant influence on radial growth and germination of the conidiospores in V. dahlia [29]. Deletion mutants of BeNEP1 and BeNEP2 were morphologically indistinguishable from the wild-type strain B. elliptica, and similar disease symptoms and radial lesion sizes were also observed [28]. Both BcNEP1 and BcNEP2 were differently expressed during the infection of Nicotiana benthamiana leaves, and equal virulence to the wild-type B. cinerea was observed in BcNEP2 or BcNEP1 replacement mutants [30]. These findings suggest that NLPs are not directly the pathogenic determinant in these plant–pathogen interaction systems.
In S. sclerotiorum strain 1980 (NCBI txid: 665079), there are two type I NLP-encoding genes, namely SsNEP2 (GenBank: XM_001586833) and SsNEP1 (GenBank: XM_001596807). Both of them contain a conserved domain of the necrosis-inducing protein (NPP1, pfam05630), which possesses a conserved heptapeptide “GHRHDWE” and one predicted disulfide bond formatted with two conserved cysteine residues. As effector candidates, they are predicted to be pathogen-associated molecular patterns (PAMPs) and associated with the broad host range of S. sclerotiorum [31,32]. During infection of Brassica napus leaves, SsNEP1 was found to be expressed at a very low level compared to SsNEP2 [23]. SsNEP2 contributes to the virulence of S. sclerotiorum by regulating reactive oxygen species (ROS) without affecting the development of mycelia [33]. In the mycoparasitic process between C. minitans and S. sclerotiourm, we found that SsNEP2 was also significantly induced 12 h post-inoculation (hpi) when in contact with C. minitans, while the expression of SsNEP1 and NLPs in C. minitans was not regulated [11]. C. minitans specifically parasitizes S. sclerotiorum, but not B. cinerea. Based on RNA-seq and the qRT-PCR analysis, NLPs were found to be slightly up-regulated or undetectable during the interaction between B. cinerea and C. minitans [34]. Thus, it is postulated that SsNEP2 may play an additional role in the mycoparasitic process besides inducing necrosis on plant cells. In this research, the function of SsNEP2 in the mycoparasitism between C. minitans and S. sclerotiorum was investigated.
2. Materials and Methods
2.1. Strains and Growth Conditions
C. minitans strain ZS-1 was originally isolated from soil in Zhushan County, China. Strain ZS-1 was used to activate the response of S. sclerotiorum 1980. Fungal strains were grown on potato dextrose agar plates (PDA, DB Biosciences, San Diego, CA, USA) at 20 °C and stored in PDA slants at 4 °C for further use [35]. Bacteria used for molecular experiments were grown on Luria–Bertani medium.
2.2. RNA Preparation and cDNA Synthesis
Mycelia of strain 1980 were cultured on a sterile cellophane membrane on PDA for 48 h. Conidia of C. minitans strain ZS-1 were shaken at 20 °C in PDB at 150 r/min for 36 h, washed with sterilized water 3 times, and re-suspended in water to 1.0 × 106 conidia/mL. Then, the suspension with germinated conidia was spread on the colony (1 mL for each plate) of S. sclerotiorum. The mycelial mixtures were sampled at 0 h (immediately after spread), 4 h (co-cultured for 4 h), 12 h, 24 h, 48 h, 72 h, and 96 h. Similarly, mycelia of S. sclerotiorum cultured for the same duration as the mixed sample were sampled at 48 h, 52 h, 60 h, 72 h, 96 h, 120 h, and 144 h. For all the samples, total RNA was extracted using RNA reagent (NewBio Industry, Tianjin, China) following the manufacturer’s instructions. To check the gene expression at different interaction time points, cDNA synthesis was conducted according to the manufacturer’s protocol using EasyScript® cDNA synthesis kits (TransGen biotechnology, Beijing, China).
2.3. Yeast Secretion Trap Screen Assay
The predicted signal peptide fragment of SsNEP2 was fused to the N-terminus of the secretion-defective invertase gene (suc2) in the vector pSUC2 and then transformed into the yeast strain YTK12 using the LiAc/SS carrier DNA/PEG method [36,37]. Yeast candidates were screened and cultured on CMD-W medium lacking tryptophan (0.67% yeast N base without amino acid, 0.075% W dropout supplement, 2% sucrose, 0.1% glucose, and 2% agar) and YPRAA (10 g/L yeast extract, 20 g/L peptone, 20 g/L raffinose, 2 mg/L antimycin A, and 2% agar) medium; strains with secretion activity were able to grow on YPRAA. The secretion sucrase activity of the candidates was assayed using 2,3,5-triphenyltetrazolium chloride (TTC). The supernatant was centrifuged and collected after the candidate transformants were incubated in a 10% sucrose solution at 30 °C for 35 min. Then, the final concentration of 0.1% TTC reagent was added and stewed at room temperature for 5 min to observe the color change in the test tube. A positive reaction changed from colorless to dark red, with the SPAvrb transformant, pUSC2 transformant, and YTK12 strains used as positive and negative controls, respectively.
2.4. Vector Construction and Fungal Transformation
Plasmid pCH, with a hygromycin phosphotransferase gene (hyg) as a marker, was used to construct the SsNEP2 RNAi vector. Sense and antisense fragments, which were repeats of a 500 bp fragment, were amplified using two primer pairs (Table 1) with full-length cDNA of SsNEP2 as the template. For the sense fragment, primers SsNEP2-SmaI F and SsNEP2-BamHI R were used. Primers SsNEP2-ClaI F and SsNEP2-EcoRV R were used to amplify the antisense fragment. The primers were designed based on the target segment using the software Primer Premier 6.0 (PREMIER Biosoft, Palo Alto, CA, USA), and restriction enzyme sequences were added at each end. cDNA was synthesized from 5 μg of total RNA of every sample using oligo(d)T in the EasyScript One-Step gDNA Removal and cDNA Synthesis SuperMix Kit (TransGen biotechnology, Beijing, China). PCR amplification was conducted with the Pfu DNA Polymerase Kit (TransGen Biotechnology, Beijing, China), and the program was as follows: 94 °C for 5 min, 94 °C for 30 s, 56 °C for 15 s, and 72 °C for 15 s, repeats of 34 cycles from the second step, followed by a final extension at 72 °C for 10 min. The fragments were cloned into a pCIT vector with a spacer fragment to make a hairpin RNAi structure. Then, the recombinant silencing sequence with a promoter and a terminator was cut using a pair of restriction enzymes, XhoI and SacI, and introduced into a pCH vector to construct pCH-SsNEP2. pCH-SsNEP2 was transferred into Agrobacterium tumefaciens EHA105 and used to transform fungal mycelia through A. tumefaciens-mediated transformation (ATMT), which was performed as described previously [38]. The transformants were selected on PDA with 100 μg/mL hygromycin B (Sigma-Aldrich, Shanghai, China).
Table 1.
Primers involved this research.
To overexpress SsNEP2 in C. minitans and S. sclerotiorum, pCETNSF-SsNEP2 was constructed with the full-length SsNEP2 CDS fragment and an EF-1α promoter and was introduced into fungal protoplasts with the help of polyethyleneglycol. The transformants were selected on PDA with a final concentration of 100 μg/mL G418 (Sigma-Aldrich, Shanghai, China). The full-length SsNEP2 CDS fragment was obtained with the primer pairs OEssNEP2-SpeI F and OEssNEP2-KpnI R. Fungal protoplasts were prepared and transformed as described by Rollins [39] and Qiao et al. [40] with modifications. Fungal protoplasts were generated in 0.8 mol/L MgSO4 lysis solution buffer containing 1% lysing enzymes from T. harzianum (Sigma-Aldrich, Shanghai, China) and 0.1% Snailase (Sigma-Aldrich, Shanghai, China) and re-suspended in STC (1.0 mol/L sorbitol, 0.05 mol/L Tris-HCl pH 8.0, and 0.05 mol/L CaCl2) at a concentration of 1.0 × 108 per milliliter.
The relative expression of SsNEP2 in transformants was determined as described below using RT-qPCR with the primer pairs RtSsNep2-F/R and normalized under the primer pairs CmActin F/R in C. minitans and β-tubulin F/R in S. sclerotiorum (Table 1).
2.5. RT-qPCR
RT-PCR (reverse transcription PCR) was used to detect the gene expression of SsNEP1 and SsNEP2 at different stages. PCR was conducted with 0.2 μL cDNA for each sample and under an annealing temperature of 56 °C using a Bio-Rad thermal cycler (Bio-Rad, Hercules, CA, USA). The PCR products were detected with 1.5% agarose electrophoresis and imaged under UV light. The PCR product of S. sclerotiorum β-tubulin was used to sterilize the total cDNA. Two independent repeats of the experiment were performed.
The relative transcripts of the NPP1-related gene and silencing efficiency of SsNEP2 were determined by RT-qPCR (quantitative reverse transcription PCR) on a Bio-Rad CFX Real-Time System (Bio-Rad, Hercules, CA, USA). Each PCR reaction contained 7.5 μL of 2×iTaq Universal SYBR Green Supermix (Bio-Rad, Hercules, CA, USA), 0.2 μL of cDNA template, 0.3 μL of each primer, and 6.7 μL of ddH2O (double distilled water). The program was as follows: 95 °C for 2 min, followed by 42 cycles of 95 °C for 15 s, 57 °C for 15 s and 72 °C for 15 s, and a cycle with 0.5 °C per second from 65 °C to 95 °C to remove the influence of the primer dimer. Total cDNA abundance in the samples was normalized against S. sclerotiorum β-tubulin. The primers used to obtain an amplicon of approximately 150 bp from each target gene are listed in Table 1. The relative expression of NLPs in S. sclerotiorum was conducted with the primer pairs RtSsNep2-F/R for SsNEP2 and the primer pairs RtSsNep1-F/R for SsNEP1. Relative gene expression was normalized under the primer pairs β-tubulin F/R. The primer pairs for RT-PCR and RT-qPCR were designed by the software Beacon Designer 7.9 (PREMIER Biosoft, Palo Alto, CA, USA). All samples were amplified in triplicate.
2.6. Mycelial Growth Assay
Mycelial growth assay was performed on PDA plates as described by Cheng et al. [41]. Strains were activated on PDA plates under 20 °C. Mycelial agar disks were taken from the colony margin with a sterilized hole punch (Φ = 5 mm), transferred face down to the center of fresh 20 mL PDA plates (Φ = 90 mm), and incubated at 20 °C. For S. sclerotiorum, the mycelial diameters were measured using a centimeter ruler every 12 h after inoculation and converted to daily data. The mycelial growth of C. minitans was measured every day after inoculation from the 3rd day to the 5th day. Mean value was taken to calculate the mycelial growth rate in centimeters every day (cm/d). Each treatment contained three replicates, and the entire experiment was repeated three times.
2.7. Parasitic Test on Mycelia and Sclerotia of S. sclerotiorum by C. minitans
The dual-culture method was used to determine the mycoparasitic ability of C. minitans to the mycelia of S. sclerotiorum [9]. S. sclerotiorum was placed on one side of the PDA plate (Φ = 90 mm), and C. minitans was placed on the opposite side of the same plate. The dual-culture plates were incubated for 30 days. To quantify the parasitic ability of the mutants, from the junction of the two fungi, the S. sclerotiorum colony was divided into four regions, and five disks from each region were punched and placed on fresh PDA plates. After seven days of incubation, the emerging colonies were judged to be those of C. minitans or S. sclerotiorum.
Parasitization of sclerotia was evaluated following the description given in [41]. Sclerotia were cultured on carrot blocks in 500 mL flasks for 30 days. Sclerotia with similar size were selected to test the parasitic ability of C. minitans. Conidia of C. minitans were collected from colonies growing on PDA for 15 days and diluted with sterilized ddH2O to 1.0 × 106 conidia/mL. Sclerotia were submerged in 50% bleach twice for 5 min to remove the microorganisms on the surface, rinsed in 70% ethanol twice for 5 min, and washed with sterilized ddH2O thrice. The surface-sterilized sclerotia were submerged into the conidial suspension of C. minitans for 30 min, half-buried in sterilized wet sand in plates, and incubated for 30 days at 20 °C. Sclerotia were taken out from the sand and dissected using a surgical knife to observe the cross-section using a stereomicroscope (Olympus SZX-16, Olympus Corporation, Tokyo, Japan). Twenty sclerotia with five repeats were used for each treatment, and the experiments were repeated twice independently.
2.8. Conidial Production of C. minitans Induced by S. sclerotiorum Culture Filtrate
To clarify the influence of SsNEP2 on C. minitans conidial production, 10 mycelial discs (Φ = 5 mm) of S. sclerotiorum were transferred to 500 mL Erlenmeyer flasks with 200 mL PDB (DB Biosciences, San Diego, CA, USA) and incubated at 150 r/min under 20 °C for four days. Then, the cultures were subjected to centrifuge at 5000 r/min for 15 min at 4 °C, and all hyphal fragments were removed by passing through a sterile 0.22 μm filter (Millipore Corporation, Danvers, MA, USA). The filtered liquid (PDB fermentation broth, FPDB) was stored in sterile tubes and buried in ice for future use. The FPDB was amended with PDA or water containing 2% agar (WA) at a 1:1 volume to make PDA-FPDB or WA-FPDB, respectively. A mycelial agar (Φ = 5 mm) of C. minitans strain ZS-1 from a 5-day colony on PDA was placed in the center of the plate with 8 mL of PDA-FPDB or WA-FPDB and incubated at 20 °C. The mycelial growth was measured using the cross method every 24 h from 48 h to 120 h. The experiment was repeated thrice independently.
Conidia of C. minitans ZS-1 formed were calculated after 15 days as follows. Four mycelial agars (Φ = 5 mm) of C. minitans were triturated and filtered with a layer of sterilized lens paper. Then, the filtered liquid was centrifuged at 12,000 r/min for 5 min to remove the liquid supernatant. Finally, the precipitate was re-suspended with sterilized water to 1 mL, and conidia were calculated using a hemocytometer (Qiujing XB.K.25., Shanghai, China). Data were logarithmically transformed and used for statistical analysis.
2.9. Conidial Germination of C. minitans Induced by S. sclerotiorum
To determine the promotion of conidial germination by the sclerotia silencing mutants, the sclerotial soak was prepared for the germination of C. minitans conidia at 20 °C. Firstly, 50 g of sclerotia from the SsNEP2 silencing mutants or the wild-type strain 1980 were sterilized as described above in method Section 2.7 and incubated in 50 mL sterilized water for 24 h at 20 °C. Then, the mixed solution was centrifuged at 5000 r/min under 4 °C for 10 min, and the supernatant was filtered through a 0.22 μm filter and used to dilute the conidia of C. minitans to 105 conidia/mL. The conidia were shaken at 150 r/min under 20 °C for 36 h to check the germination with a light microscope. The sterilized water was used as the negative control, and all the trials were conducted with four repeats for each treatment.
2.10. Statistical Analysis
The significant value of the differences in all analyses was evaluated using the least significant difference test with the ANOVA program in the SAS 9.2 software (SAS Institute, Cary, NC, USA) at the significance level of p < 0.01.
3. Results
3.1. SsNEP2 Is Highly Expressed During the Mycoparasitic Process
The expression of SsNEP1 and SsNEP2 was examined during the interaction between S. sclerotiorum and C. minitans. SsNEP2 was expressed at a very low level in S. sclerotiorum cultured on PDA, while it was strongly induced at 12 hpi and 24 hpi when parasitized by C. minitans, and the highest transcript level was detected at 24 hpi. Both during the mycoparasitic process and during culturing on PDA, SsNEP1 was expressed at a relatively lower level compared to SsNEP2 (Figure 1a–d). The results suggest that SsNEP2, not SsNEP1, may be involved in the interaction between S. sclerotiorum and C. minitans. Therefore, SsNEP1 was chosen to carry out further study.
Figure 1.
Expression of SsNEP1 and SsNEP2 in S. sclerotiorum. (a) RT-PCR detection of the gene expression of SsNEP1 and SsNEP2 in S. sclerotiorum cultured on PDA. S48, S52, S60, S72, S96, S120, and S144 represent the incubating stage of S. sclerotiorum on PDA for 48 h, 52 h, 60 h, 72 h, 96 h, 120 h, and 144 h, respectively. β-tubulin was used as a reference. H2O was used as the negative control. M: DNA ladder DL2000 (TaKaRa, Dalian, China). The primer pairs were Rt-SsNEP2-F/R for SsNEP2 and Rt-SsNEP1-F/R for SsNEP1. The primer sequences are listed in Table 1. (b) Fluorescence quantitative PCR detection of gene expression of SsNEP1 and SsNEP2 in S. sclerotiorum cultured on PDA. The normalized gene expression at 48 h was set as 1. The expression of β-tubulin was used to normalize different samples. (c) The expression of SsNEP1 and SsNEP2 in S. sclerotiorum induced by C. minitans at different stages. SC0, SC4, SC12, SC24, SC48, SC72, and SC96 represent the interaction stages of S. sclerotiorum with C. minitans for 0 h, 4 h, 12 h, 24 h, 48 h, 72 h, and 96 h, respectively. (d) The transcript level of SsNEP1 and SsNEP2 in S. sclerotiorum induced by C. minitans at different stages. The normalized gene expression at 0 h was set as 1. (e) Secretory identification of SsNEP2 using the yeast secretion trap system. SPAvrb is the positive control. pSUC2 is the empty vector control. YTK12 is the yeast control. (f) Color identification of the samples from (e) by TTC. TTC is 2,3,5-triphenyltetrazolium chloride. TTC changed from colorless to red, indicating a responsive activity.
SsNEP2 is predicted to encode a secreted signal peptide at the N-terminus. The secretory activity was identified based on a yeast secretion trap system (Figure 1e). Yeast containing the SsNEP2 plasmid SPSsNep2 could degrade sucrose, causing TTC to change from colorless to red, indicating the secretory activity of the signal peptide (Figure 1f).
3.2. Silencing of SsNEP2 Has No Influence on the Growth of S. sclerotiorum
Three silencing mutants (SsNEP2-sl-4, SsNEP2-sl-9, and SsNEP2-sl-19) and three overexpressed transformants (OESsNep2-Ss-3, OESsNep2-Ss-5, and OESsNep2-Ss-10) of S. sclerotiorum were obtained and confirmed by RT-qPCR (Figure 2a). Compared to the wild-type strain 1980, the silencing mutants displayed similar colony morphology, growth rate, hyphal tips, and sclerotial formation, while the overexpressed transformants grew much more slowly with more branches (Figure 2b). Overexpression of SsNEP2 in S. sclerotiorum led to irregular colonies and fewer and smaller sclerotia compared to strain 1980 (Figure 2c,d). The results suggest that silencing of SsNEP2 has no influence on the growth of S. sclerotiorum, while overexpression of SsNEP2 leads to significant inhibition of mycelial growth with more branches of mycelia.
Figure 2.
SsNEP2 mutants of S. sclerotiorum. (a) The transcript level of SsNEP2 cultured for 36 h on PDA. Three silencing mutants are represented as SsNEP2-sl-4, SsNEP2-sl-9, and SsNEP2-sl-19. OESsNep2-Ss-3, OESsNep2-Ss-5, and OESsNep2-Ss-10 represent the overexpressed transformants of S. sclerotiorum. (b) Radial growth of all the strains on PDA. The significance level is p < 0.01 and the significant differences are distinguished by capital letters of A, B and C at the top of bar chart. (c) Colony morphology of all the strains cultured on PDA for 7 days at 20 °C. (d) Hyphal tips of all strains growing on PDA for 36 h.
3.3. Silencing of SsNEP2 in S. sclerotiorum Inhibits the Conidial Production of C. minitans
To evaluate the influence of S. sclerotiorum on C. minitans, strain ZS-1 was incubated on PDA-FPDB (PDA amended with fermentation broth of S. sclerotiorum) and WA-FPDB (water agar amended with fermentation broth of S. sclerotiorum) (Figure 3a,b). An average mycelial growth rate of 0.09 cm/d was observed when cultured on WA-PDA of SsNEP2-sl-19, which was significantly slower than on PDB negative control and other treatments. No significant influence on the mycelial growth of strain ZS-1 was detected on PDA-FPDB (Figure 3c).
Figure 3.
C. minitans affected by SsNEP2. (a) Colony morphology of C. minitans strain ZS-1 incubated at 20 °C for 15 days on PDA-FPDB (PDA amended with an equal volume of filter fermentation broth of S. sclerotiorum shaken in PDB for four days). (b) Colony morphology of C. minitans strain ZS-1 incubated at 20 °C for 15 days on WA-FPDB (water agar culture amended with filter fermentation broth of S. sclerotiorum). (c) Mycelial growth of C. minitans on PDA-FPDB and WA-FPDB. The significance level is p < 0.01 and the significant differences are distinguished by capital letters of A, B and C at the top of bar chart. (d) Conidiation of C. minitans cultured on PDA-FPDB or WA-FPDB with 15 days. The significance level is p < 0.01 and the significant differences are distinguished by a capital letter at the top of bar chart.
Approximately 3.75 × 107, 3.48 × 107, and 2.85 × 107 conidia/mL were produced when strain ZS-1 was incubated on PDA-FPDB of SsNEP2-sl-4, SsNEP2-sl-9, and SsNEP2-sl-19, respectively, which were fewer than those produced on the PDA-FPDB of strain 1980 (4.73 × 107 conidia/mL) and the negative control of PDB (1.15 × 108 conidia/mL) (Figure 3d). However, no conidium was formed when strain ZS-1 was incubated on WA-FPDB of all SsNEP2 silencing mutants (Figure 3d). Thus, the expression of SsNEP2 is essential for the conidiation of C. minitans during the mycoparasitic process.
3.4. Silencing of SsNEP2 in S. sclerotiorum Enhances Resistance to the Parasitism of C. minitans
To clarify the role of SsNEP2 in the mycoparasitism between S. sclerotiorum and C. minitans, the mycoparasitic ability of ZS-1 on the SsNEP2 transformants was evaluated by dual culture. Compared to the parasitism on S. sclerotiorum 1980, strain ZS-1 exhibited significantly weaker parasitic ability on silencing mutants and formed fewer pycnidia, while stronger parasitism and more pycnidia were observed on the colony of the overexpressed transformants of S. sclerotiorum (Figure 4).
Figure 4.
Mycelial parasitism of C. minitans against the SsNEP2 mutants of S. sclerotiorum. (a) Dual culture of C. minitans and the SsNEP2 silencing mutants for 30 days. ZS-1 means C. minitans. (b) Dual culture of C. minitans and the SsNEP2 overexpressed transformants for 20 days. (c) Schematic diagram showing the number of agar disks that gave rise to either C. minitans (black circle), S. sclerotiorum (hollow circle), or both (gray circle). Each circle represents a colony developed from a mycelial agar disk sampled from zones I, II, III, or IV between the inoculation sites of C. minitans and S. sclerotiorum in a dual culture. The appearance of S. sclerotiorum colonies indicates that C. minitans has not yet parasitized S. sclerotiorum in this region. Similarly, the presence of C. minitans colonies suggests that S. sclerotiorum was eliminated by C. minitans. The occurrence of colonies of both C. minitans and S. sclerotiorum indicates that C. minitans has not yet completely destroyed the hypha of S. sclerotiorum.
When coating sclerotia of S. sclerotiorum with conidia, mycelia of C. minitans appeared 5 to 7 days earlier on the silencing mutants than on strain 1980 (Figure 5a). Approximately 30% germinated conidia were detected in the sclerotial soak of strain 1980, while an average of 45% conidia germinated in the sclerotial soak of the SsNEP2 silencing mutants (Figure 5b). Sclerotia of all strains were parasitized after 30 days of inoculation, and pycnidia were formed on the surface of the parasitized sclerotia (Figure 5c). The rot index of silencing mutants was much less than that of the wild strain 1980 (Figure 5d). These results demonstrate that silencing of SsNEP2 in S. sclerotiorum promotes conidial germination and enhances resistance to the parasitism of C. minitans.
Figure 5.
Parasitism of C. minitans to the sclerotia of S. sclerotiorum. (a) Sclerotia of SsNEP2 silencing mutants were covered with mycelia of C. minitans after inoculation with C. minitans conidia for 5 days at 20 °C. Strain 1980 is S. sclerotiorum strain 1980 (b) The conidial germination rate of C. minitans cultured in sclerotial soaked for 24 h at 20 °C. (c) Sclerotia of S. sclerotiorum parasitized by C. minitans 30 days after inoculation. Pycnidia formed on the surface of sclerotia (red arrows). (d) Rot index of sclerotia of the silencing SsNEP2 mutants parasitized by C. minitans. The surface-sterilized sclerotia of mutants and strain 1980 of S. sclerotiorum were submerged into the conidial suspension of C. minitans for 30 min, half-buried in sterilized wet sand in plates, and incubated for 30 days at 20 °C. Twenty sclerotia with five repeats were used for each strain, and the experiment was repeated twice independently. The rot index of sclerotia was evaluated according to the described method [41]. The significance level is p < 0.01 and the significant differences are distinguished by a capital letter at the top of bar chart.
3.5. Overexpression of SsNEP2 Promotes the Growth of C. minitans
As a secreted protein-encoding gene, the expression of SsNEP2 was induced during the interaction between S. sclerotiorum and C. minitans. The resistance to parasitism by C. minitans was enhanced by the silencing mutants. It is postulated that SsNEP2 may enhance the parasitic ability and biocontrol potential of C. minitans on S. sclerotiorum. To further explore the parasitic effect on C. minitans, SsNEP2 was introduced into strain ZS-1. Three SsNEP2 overexpressed mutants in C. minitans (OESsNep2-Cm-2, OESsNep2-Cm-3, and OESsNep2-Cm-4) were obtained (Figure 6a,b). There was no significant difference in the colony morphology and conidiation of SsNEP2 overexpressed mutants compared to those of strain ZS-1 on PDA (Figure 6c). The average mycelial growth rate of three overexpressed mutants, namely OESsNep2-Cm-2, OESsNep2-Cm-3, and OESsNep2-Cm-4, was 0.60 cm/d, 0.60 cm/d, and 0.61 cm/d, respectively, which was significantly higher than that of strain ZS-1 (0.57 cm/d) (Figure 6d).
Figure 6.
SsNEP2 overexpressed mutants of C. minitans. (a) Colony morphology of SsNEP2 overexpressed mutants of C. minitans OESsNep2-Cm-2, OESsNep2-Cm-3, and OESsNep2-Cm-4. (b) qPCR detection of the expression of SsNEP2 in C. minitans. (c) Conidial production of SsNEP2 overexpressed mutants of C. minitans. (d) Growth rate of the SsNEP2 overexpressed mutants of C. minitans. (e,f) Sclerotial parasitism of the SsNEP2 overexpressed mutants of C. minitans. Sclerotia are from the S. sclerotiorum strain 1980. ZS-1 represents the C. minitans strain ZS-1. (g,h) Mycelium parasitism of SsNEP2 overexpressed mutants of C. minitans on PDA. Each circle represents a colony developed from a mycelial agar disk sampled from zones I, II, III, or IV between the inoculation sites of C. minitans and S. sclerotiorum in a dual culture. (i) Mycelial parasitism of SsNEP2 overexpressed mutants of C. minitans on water agar. (j) The colony diameter of C. minitans from the samples of (e). (k) The conidial production of C. minitans from the samples of (e). The significance level is p < 0.01 and the significant differences are distinguished by a capital letter at the top of bar chart.
3.6. Expression of SsNEP2 in C. minitans Improves Parasitism to Mycelia of S. sclerotiorum
Three overexpressed mutants in C. minitans, namely OESsNep2-Cm-2, OESsNep2-Cm-3, and OESsNep2-Cm-4, were used to explore the function of SsNEP2 during the mycoparasitic process. A similar rot index of sclerotia and parasitism to the mycelia of S. sclerotiorum by dual culture was observed among all strains of C. minitans cultured on PDA (Figure 6e–h). However, when growing on the colony of S. sclerotiorum for 20 days, the average colony diameter of OESsNEP2-Cm-2, OESsNEP2-Cm-3, and OESsNEP2-Cm-4 was 2.94 cm, 2.99 cm, and 3.05 cm, which was significantly larger than that of strain ZS-1 (2.22 cm) (Figure 6i,j), and more conidia were formed by overexpressed mutants of C. minitans than strain ZS-1 (Figure 6k). Therefore, the overexpression of SsNEP2 in C. minitans improves mycoparasitic ability against mycelia of S. sclerotiorum and conidial production there.
3.7. Expression of SsNEP2 in C. minitans Restores Conidiation and Parasitism to Silencing Mutants of S. sclerotiorum
To further evaluate the role of SsNEP2 in mycoparasitism, two SsNEP2 overexpressed mutants of C. minitans, namely OESsNep2-Cm-2 and OESsNep2-Cm-3, were dual cultured with the silencing mutants SsNEP2-sl-3 and SsNEP2-sl-9, respectively. The parasitism of OESsNep2-Cm-2 and OESsNep2-Cm-3 to SsNEP2-sl-3 and SsNEP2-sl-9 was much stronger than ZS-1, and they also produced more pycnidia (Figure 7). The results indicate that the overexpression of SsNEP2 in C. minitans restores the effects on mycoparasitic ability and conidial production by the silencing of SsNEP2 in S. sclerotiorum during the interaction process.
Figure 7.
Mycelial parasitism between SsNEP2 silencing transformants of S. sclerotiorum and expression mutants of C. minitans. (a) Dual culture of C. minitans and S. sclerotiorum for 20 days under 20 °C. ZS-1 represents the C. minitans strain ZS-1. (b) Results of the dual culture of (a). Schematic diagram showing the number of agar disks that gave rise to either C. minitans (black circle), S. sclerotiorum (hollow circle), or both (gray circle). Each circle represents a colony developed from a mycelial agar disk sampled from zones I, II, III, or IV between the inoculation sites of C. minitans and S. sclerotiorum in a dual culture.
4. Discussion
NLP expression was significantly up-regulated at the early stage of infection between the pathogens and their hosts, and the role of NLPs was diversified during infection [18,33,42,43,44]. Most NLPs played dual roles in plant–pathogen interactions as toxin-like virulence factors and as triggers of plant innate immune responses, inducing plant necrosis [15,18,27,45,46,47,48,49]. NPP1 in plant leaves resulted in transcript accumulation of pathogenesis-related (PR) genes, production of ROS and ethylene, callose apposition, and HR-like cell death [14,19,32,42]. The synthesized peptides of Valsa mali VmNLP2 triggered a strong immune response in Arabidopsis thaliana and induced cell death when transiently expressed in Nicotiana benthamiana [50]. In Theobroma cacao, necrosis was observed on leaves after NEP1 treatment, and expression of the defense-related gene TcWRKY-1 was enhanced, while expression of TcChiB, TcLhca-1, and TcrbcS was repressed [51]. Interestingly, seven NLPs were strikingly up-regulated during the early stages of the infection process between Plasmopara viticola and grapevine leaves, while only PvNLP7 could induce necrosis and disease resistance in N. benthamiana by A. tumefaciens-mediated transient expression [52]. When there was infiltration of recombinant NLPs into tobacco and Arabidopsis leaves, none of the 12 identified HaNLPs in Hyaloperonospora arabidopsidis was able to induce necrosis [53]. Meanwhile, significantly reduced virulence on leaves of tobacco or Arabidopsis and decreased accumulation of ROS were reported in the knock-out of SsNEP2 in S. sclerotiorum [33]. The disruption of NLP in Stemphylium lycopersici led to low conidial production, weak effects on its adaptation to oxidative stress, and significant reduction in its virulence on tomato [54]. However, as described in the Introduction section, in most plant pathogens, the absence of NLPs did not affect their pathogenicity [21,22,28,30,43]. These suggest that NLPs might be functional as PAMPs in inducing resistance and necrosis but not as a major virulence determinant during most infection systems of fungi and their host plants.
NLPs are widely present in fungi with diverse functions, e.g., induction of ROS accumulation and involvement in host selection. In S. sclerotiorum, SsNEP2, encoding a putative secreted effector, was up-regulated at 24 h (log FC = 5.17) after inoculation on plants [55] and was reported to cause necrosis on tobacco leaves [23]. Further study showed that SsNEP2 served as a PAMP to trigger immunity of plants, and the loss of SsNEP2 decreased the virulence to tobacco or Arabidopsis [33]. Interestingly, when coming in contact with C. minitans for 12 hpi, SsNEP2 was also significantly up-regulated (log FC = 4.91) in S. sclerotiorum [11] and up-regulated with log FC = 9.88 for 24 hpi. Silencing of SsNEP2 led to enhanced resistance to parasitism of C. minitans. In this study, an additional function of SsNEP2 was explored in S. sclerotiorum during interaction with the mycoparasite C. minitans.
The parasitism of C. minitans against S. sclerotiorum is a comprehensive and complex process. Several factors in C. minitans that reduce the mycoparasitism ability have been analyzed, including cyclic GMP (cGMP), cyclic AMP (cAMP), mitogen-activated protein (MAP) kinase cascade, peroxisome biogenesis gene (CmPEX6) [8], NADPH oxidase complex, autophagy, PIF1 DNA helicase gene [56], homotypic fusion and vacuolar protein-sorting gene (CmVps39) [57], oxalate decarboxylase-coding genes [9,58], altered inheritance of mitochondria protein 24 (CmAim24) [59], and melanin synthesis-related gene 1 (CmMR1) [60], etc. However, research on S. sclerotiorum and the activation of mycoparasitism remains rare. Silencing of SsNEP2, which enhanced the resistance to parasitism of C. minitans, could be a method by which parasitic ability is not activated. The first layer of the plant surveillance system invokes the recognition of microbes by employing pattern recognition receptors [61,62,63]. A class of NLPs has been described as PAMPs from mostly phytopathogens [15,16,47]. NLPs are cytotoxic to eudicot plants, as they disturb the plant plasma membrane by binding to specific plant membrane sphingolipid receptors [64]. SsNEP2 expressed in C. minitans improved mycelial parasitism on S. sclerotiorum and restored the parasitic ability affected by the silencing of SsNEP2 of S. sclerotiorum, while the silencing of SsNEP2 in S. sclerotiorum inhibited the production of C. minitans conidia but promoted their germination. Therefore, it could be concluded that SsNEP2 might also act as a PAMP to be recognized by C. minitans and further activate the parasitic system between S. sclerotiorum and C. minitans. As a specific parasitic fungus of S. sclerotiorum, C. minitans is completely non-pathogenic to plants, and its biocontrol value has been verified [6,65]. SsNEP2 can be applied to enhance the biological potential of C. minitans.
Author Contributions
Conceptualization, D.J., J.C., J.X. and Y.F.; resources, D.J., J.C. and J.X.; formal analysis, H.Z. and Z.Z.; investigation, H.Z., Z.Z., Y.X. and H.W.; data curation, H.Z., Z.Z. and Y.X.; writing—original draft preparation, H.Z., Z.Z. and Y.X.; writing—review and editing, H.Z. and Y.F. All authors have read and agreed to the published version of the manuscript.
Funding
This research was funded by “the National Natural Science Foundation of China, grant number 32102277”, “the Youth Top-notch Talent Training Program of Hubei Academy of Agricultural Sciences”, and “the earmarked fund for CARS-12”.
Institutional Review Board Statement
Not applicable.
Informed Consent Statement
Not applicable.
Data Availability Statement
The original contributions presented in this study are included in the article. Further inquiries can be directed to the corresponding author.
Acknowledgments
We thank Associate Researcher Zhuoren Wang from Hubei Academy of Agricultural Sciences for his assistance during the research process.
Conflicts of Interest
The authors declare no conflicts of interest.
Abbreviations
The following abbreviations are used in this manuscript:
| NEP1 | necrosis- and ethylene-inducing peptide 1 |
| NLP | NEP1-like protein |
| NPP1 | The necrosis-inducing protein |
| PAMP | pathogen-associated molecular patterns |
| ROS | regulating reactive oxygen species |
| hpi | hours post-inoculation |
| PDA | potato dextrose agar plates |
| suc2 | secretion-defective invertase gene |
| CMD-W | a medium lacking tryptophan, 0.67% yeast N base without amino acid, 0.075% W dropout supplement, 2%sucrose, 0.1% glucose, and 2% agar |
| YPRAA | a medium containing 10 g/L yeast extract, 20 g/L peptone, 20 g/L raffinose, 2 mg/L antimycin A, and 2% agar |
| TTC | 2,3,5-triphenyltetrazolium chloride |
| ATMT | Agrobacterium tumefaciens-mediated transformation |
| STC | a kind of medium containing 1.0 mol/L sorbitol, 0.05 mol/L Tris-HCl pH 8.0, and 0.05 mol/L CaCl2 |
| RT-PCR | reverse transcription PCR |
| RT-qPCR | quantitative reverse transcription PCR |
| ddH2O | double distilled water |
| FPDB | PDB fermentation broth |
| PDA-FPDB | filtered FPDB amended with PDA at 1:1 volume |
| WA-FPDB | filtered FPDB amended with water containing 2% agar at 1:1 volume |
References
- Boland, G.J.; Hall, R. Index of plant hosts of Sclerotinia sclerotiorum. Can. J. Plant Pathol. 1994, 16, 93–108. [Google Scholar] [CrossRef]
- Bolton, M.D.; Thomma, B.P.; Nelson, B.D. Sclerotinia sclerotiorum (Lib.) de Bary: Biology and molecular traits of a cosmopolitan pathogen. Mol. Plant Pathol. 2006, 7, 1–16. [Google Scholar] [CrossRef]
- Taylor, A.; Coventry, E.; Handy, C.; West, J.S.; Young, C.S.; Clarkson, J.P. Inoculum potential of Sclerotinia sclerotiorum sclerotia depends on isolate and host plant. Plant Pathol. 2018, 67, 1286–1295. [Google Scholar] [CrossRef]
- Zhu, Y.; Wu, C.; Deng, Y.; Yuan, W.; Zhang, T.; Lu, J. Recent advances in virulence of a broad host range plant pathogen Sclerotinia sclerotiorum: A mini-review. Front. Microbiol. 2024, 15, 1424130. [Google Scholar] [CrossRef] [PubMed]
- Campbell, W.A. A new species of Coniothyrium parasitic on sclerotia. Mycologia 1947, 39, 190–195. [Google Scholar] [CrossRef]
- Elsheshtawi, M.; Elkhaky, M.T.; Sayed, S.R.; Bahkali, A.H.; Mohammed, A.A.; Gambhir, D.; Mansour, A.S.; Elgorban, A.M. Integrated control of white rot disease on beans caused by Sclerotinia sclerotiorum using Contans and reduced fungicides application. Saudi J. Biol. Sci. 2017, 24, 405–409. [Google Scholar] [CrossRef] [PubMed]
- Jones, D.; Gordon, A.H.; Bacon, J.S. Co-operative action by endo- and exo-beta-(1 leads to 3)-glucanases from parasitic fungi in the degradation of cell-wall glucans of Sclerotinia sclerotiorum (Lib.) de Bary. Biochem. J. 1974, 140, 47–55. [Google Scholar] [CrossRef]
- Wei, W.; Zhu, W.; Cheng, J.; Xie, J.; Li, B.; Jiang, D.; Li, G.; Yi, X.; Fu, Y. CmPEX6, a gene involved in peroxisome biogenesis, is essential for parasitism and conidiation by the sclerotial parasite Coniothyrium minitans. Appl. Environ. Microbiol. 2013, 79, 3658–3666. [Google Scholar] [CrossRef] [PubMed]
- Zeng, L.M.; Zhang, J.; Han, Y.C.; Yang, L.; Wu, M.D.; Jiang, D.H.; Chen, W.; Li, G.Q. Degradation of oxalic acid by the mycoparasite Coniothyrium minitans plays an important role in interacting with Sclerotinia sclerotiorum. Environ. Microbiol. 2014, 16, 2591–2610. [Google Scholar] [CrossRef]
- Yang, X.; Yang, J.; Li, H.; Niu, L.; Xing, G.; Zhang, Y.; Xu, W.; Zhao, Q.; Li, Q.; Dong, Y. Overexpression of the chitinase gene CmCH1 from Coniothyrium minitans renders enhanced resistance to Sclerotinia sclerotiorum in soybean. Transgenic Res. 2020, 29, 187–198. [Google Scholar] [CrossRef]
- Zhao, H.; Zhou, T.; Xie, J.; Cheng, J.; Jiang, D.; Fu, Y. Host transcriptional response of Sclerotinia sclerotiorum induced by the mycoparasite Coniothyrium minitans. Front. Microbiol. 2020, 11, 183. [Google Scholar] [CrossRef] [PubMed]
- Bailey, B.A. Purification of a protein from culture filtrates of Fusarium oxysporum that induces ethylene and necrosis in leaves of Erythroxylum coca. Phytopathology 1995, 85, 1250–1255. [Google Scholar] [CrossRef]
- Bailey, B.A.; Apel-Birkhold, P.C.; Akingbe, O.O.; Ryan, J.L.; O’Neill, N.R.; Anderson, J.D. Nep1 protein from Fusarium oxysporum enhances biological control of opium poppy by Pleospora papaveracea. Phytopathology 2000, 90, 812–818. [Google Scholar] [CrossRef]
- Fellbrich, G.; Romanski, A.; Varet, A.; Blume, B.; Brunner, F.; Engelhardt, S.; Felix, G.; Kemmerling, B.; Krzymowska, M.; Nürnberger, T. NPP1, a Phytophthora-associated trigger of plant defense in parsley and Arabidopsis. Plant J. 2002, 32, 375–390. [Google Scholar] [CrossRef] [PubMed]
- Pemberton, C.L.; Salmond, G.P.C. The Nep1-like proteins-a growing family of microbial elicitors of plant necrosis. Mol. Plant Pathol. 2004, 5, 353–359. [Google Scholar] [CrossRef] [PubMed]
- Gijzen, M.; Nürnberger, T. Nep1-like proteins from plant pathogens: Recruitment and diversification of the NPP1 domain across taxa. Phytochemistry 2006, 67, 1800–1807. [Google Scholar] [CrossRef] [PubMed]
- Oome, S.; Van den Ackerveken, G. Comparative and functional analysis of the widely occurring family of Nep1-like proteins. Mol. Plant Microbe Interact. 2014, 27, 1081–1094. [Google Scholar] [CrossRef]
- Lenarčič, T.; Pirc, K.; Hodnik, V.; Albert, I.; Borišek, J.; Magistrato, A.; Nürnberger, T.; Podobnik, M.; Anderluh, G. Molecular basis for functional diversity among microbial Nep1-like proteins. PLoS Pathog. 2019, 15, 1007951. [Google Scholar] [CrossRef] [PubMed]
- Schoonbeek, H.J.; Yalcin, H.A.; Burns, R.; Taylor, R.E.; Casey, A.; Holt, S.; Van den Ackerveken, G.; Wells, R.; Ridout, C.J. Necrosis and ethylene-inducing-like peptide patterns from crop pathogens induce differential responses within seven brassicaceous species. Plant Pathol. J. 2022, 71, 2004–2016. [Google Scholar] [CrossRef] [PubMed]
- Feng, B.Z.; Zhu, X.P.; Fu, L.; Lv, R.F.; Storey, D.; Tooley, P.; Zhang, X.G. Characterization of necrosis-inducing NLP proteins in Phytophthora capsici. BMC Plant Biol. 2014, 14, 126. [Google Scholar] [CrossRef] [PubMed]
- Fang, Y.-L.; Peng, Y.-L.; Fan, J. The Nep1-like protein family of Magnaporthe oryzae is dispensable for the infection of rice plants. Sci. Rep. 2017, 7, 4372. [Google Scholar] [CrossRef]
- Staats, M.; van Baarlen, P.; Schouten, A.; van Kan, J.A.; Bakker, F.T. Positive selection in phytotoxic protein-encoding genes of Botrytis species. Fungal Genet. Biol. 2007, 44, 52–63. [Google Scholar] [CrossRef] [PubMed]
- Bashi, D.Z.; Hegedus, D.D.; Buchwaldt, L.; Rimmer, S.R.; Borhan, M.H. Expression and regulation of Sclerotinia sclerotiorum necrosis and ethylene-inducing peptides (NEPs). Mol. Plant Pathol. 2010, 11, 43–53. [Google Scholar] [CrossRef]
- Baroncelli, R.; Piaggeschi, G.; Fiorini, L.; Bertolini, E.; Zapparata, A.; Pè, M.E.; Sarrocco, S.; Vannacci, G. Draft whole-genome sequence of the biocontrol agent Trichoderma harzianum T6776. Genome Announc. 2015, 3, e00647-15. [Google Scholar] [CrossRef]
- Sun, Z.B.; Sun, M.H.; Li, S.D. Identification of mycoparasitism-related genes in Clonostachys rosea 67-1 active against Sclerotinia sclerotiorum. Sci. Rep. 2015, 5, 18169. [Google Scholar] [CrossRef]
- Schouten, A.; van Baarlen, P.; van Kan, J.A. Phytotoxic Nep1-like proteins from the necrotrophic fungus Botrytis cinerea associate with membranes and the nucleus of plant cells. New Phytol. 2008, 177, 493–505. [Google Scholar] [CrossRef] [PubMed]
- Qutob, D.; Kemmerling, B.; Brunner, F.; Kufner, I.; Engelhardt, S.; Gust, A.A.; Luberacki, B.; Seitz, H.U.; Stahl, D.; Rauhut, T.; et al. Phytotoxicity and innate immune responses induced by Nep1-like proteins. Plant Cell 2006, 18, 3721–3744. [Google Scholar] [CrossRef]
- Staats, M.; Van Baarlen, P.; Schouten, A.; Van Kan, J.A.L. Functional analysis of NLP genes from Botrytis elliptica. Mol. Plant Pathol. 2007, 8, 209–214. [Google Scholar] [CrossRef] [PubMed]
- Santhanam, P.; van Esse, H.P.; Albert, I.; Faino, L.; Nurnberger, T.; Thomma, B.P.H.J. Evidence for functional diversification within a fungal NEP1-like protein family. Mol. Plant Microbe Interact. 2013, 26, 278–286. [Google Scholar] [CrossRef]
- Arenas, Y.C.; Kalkman, E.R.I.C.; Schouten, A.; Dieho, M.; Vredenbregt, P.; Uwumukiza, B.; Ruiz, M.O.; Van Kan, J.A.L. Functional analysis and mode of action of phytotoxic Nep1-like proteins of Botrytis cinerea. Physiol. Mol. Plant Pathol. 2010, 74, 376–386. [Google Scholar] [CrossRef]
- Guyon, K.; Balagué, C.; Roby, D.; Raffaele, S. Secretome analysis reveals effector candidates associated with broad host range necrotrophy in the fungal plant pathogen Sclerotinia sclerotiorum. BMC Genom. 2014, 15, 336. [Google Scholar] [CrossRef] [PubMed]
- Ren, C.X.; Chen, S.Y.; He, Y.H.; Xu, Y.P.; Yang, J.; Cai, X.Z. Fine-tuning of the dual-role transcription factor WRKY8 via differential phosphorylation for robust broad-spectrum plant immunity. Plant. Commun. 2024, 5, 101072. [Google Scholar] [CrossRef]
- Yang, C.; Li, W.; Huang, X.; Tang, X.; Qin, L.; Liu, Y.; Xia, Y.; Peng, Z.; Xia, S. SsNEP2 contributes to the virulence of Sclerotinia sclerotiorum. Pathogens 2022, 11, 446. [Google Scholar] [CrossRef] [PubMed]
- Zhou, T. Preliminary Studies on Interaction Between Coniothyrium minitans and Sclerotinia sclerotiorum and Botrytis cinerea. Master’s Thesis, Huazhong Agricultural University, Wuhan, China, 2011. [Google Scholar]
- Li, M.; Gong, X.; Zheng, J.; Jiang, D.; Fu, Y.; Hou, M. Transformation of Coniothyrium minitans, a parasite of Sclerotinia sclerotiorum, with Agrobacterium tumefaciens. FEMS Microbiol. Lett. 2005, 243, 323–329. [Google Scholar] [CrossRef] [PubMed]
- Lee, S.-J.; Kim, B.-D.; Rose, J.K.C. Identification of eukaryotic secreted and cell surface proteins using the yeast secretion trap screen. Nat. Protoc. 2006, 1, 2439–2447. [Google Scholar] [CrossRef] [PubMed]
- Gietz, R.D.; Schiestl, R.H. Large-scale high-efficiency yeast transformation using the LiAc/SS carrier DNA/PEG method. Nat. Protoc. 2007, 2, 38–41. [Google Scholar] [CrossRef] [PubMed]
- Weld, R.J.; Eady, C.C.; Ridgway, H.J. Agrobacterium-mediated transformation of Sclerotinia sclerotiorum. J. Microbiol. Methods 2006, 65, 202–207. [Google Scholar] [CrossRef] [PubMed]
- Rollins, J.A. The Sclerotinia sclerotiorum pac1 gene is required for sclerotial development and virulence. Mol. Plant Microbe Interact. 2003, 16, 785–795. [Google Scholar] [CrossRef]
- Qiao, L.; Lan, C.; Capriotti, L.; Ah-Fong, A.; Nino Sanchez, J.; Hamby, R.; Heller, J.; Zhao, H.; Glass, N.L.; Judelson, H.S.; et al. Spray-induced gene silencing for disease control is dependent on the efficiency of pathogen RNA uptake. Plant Biotechnol. J. 2021, 19, 1756–1768. [Google Scholar] [CrossRef] [PubMed]
- Cheng, J.; Jiang, D.; Yi, X.; Fu, Y.; Li, G.; Whipps, J.M. Production, survival and efficacy of Coniothyrium minitans conidia produced in shaken liquid culture. FEMS Microbiol. Lett. 2003, 227, 127–131. [Google Scholar] [CrossRef] [PubMed]
- Gouveia, C.; Santos, R.B.; Paiva-Silva, C.; Buchholz, G.; Malhó, R.; Figueiredo, A. The pathogenicity of Plasmopara viticola: A review of evolutionary dynamics, infection strategies and effector molecules. BMC Plant Biol. 2024, 24, 327. [Google Scholar] [CrossRef]
- Motteram, J.; Kufner, I.; Deller, S.; Brunner, F.; Hammond-Kosack, K.E.; Nurnberger, T.; Rudd, J.J. Molecular characterization and functional analysis of MgNLP, the sole NPP1 domain-containing protein, from the fungal wheat leaf pathogen Mycosphaerella graminicola. Mol. Plant Microbe Interact. 2009, 22, 790–799. [Google Scholar] [CrossRef] [PubMed]
- Seidl, M.F.; Van den Ackerveken, G. Activity and phylogenetics of the broadly occurring family of microbial Nep1-Like proteins. Annu. Rev. Phytopathol. 2019, 57, 367–386. [Google Scholar] [CrossRef]
- Keates, S.E.; Kostman, T.A.; Anderson, J.D.; Bailey, B.A. Altered gene expression in three plant species in response to treatment with Nep1, a fungal protein that causes necrosis. Plant Physiol. 2003, 132, 1610–1622. [Google Scholar] [CrossRef] [PubMed]
- Jones, J.D.; Dangl, J.L. The plant immune system. Nature 2006, 444, 323–329. [Google Scholar] [CrossRef] [PubMed]
- Oome, S.; Raaymakers, T.M.; Cabral, A.; Samwel, S.; Bohm, H.; Albert, I.; Nurnberger, T.; Van Den Ackerveken, G. Nep1-like proteins from three kingdoms of life act as a microbe-associated molecular pattern in Arabidopsis. Proc. Natl. Acad. Sci. USA 2014, 111, 16955–16960. [Google Scholar] [CrossRef] [PubMed]
- Irieda, H.; Inoue, Y.; Mori, M.; Yamada, K.; Oshikawa, Y.; Saitoh, H.; Uemura, A.; Terauchi, R.; Kitakura, S.; Kosaka, A.; et al. Conserved fungal effector suppresses PAMP-triggered immunity by targeting plant immune kinases. Proc. Natl. Acad. Sci. USA 2019, 116, 496–505. [Google Scholar] [CrossRef]
- Pirc, K.; Hodnik, V.; Snoj, T.; Lenarčič, T.; Caserman, S.; Podobnik, M.; Böhm, H.; Albert, I.; Kotar, A.; Plavec, J.; et al. Nep1-like proteins as a target for plant pathogen control. PLoS Pathog. 2021, 17, e1009477. [Google Scholar] [CrossRef]
- Liu, J.; Nie, J.; Chang, Y.; Huang, L. Nep1-like proteins from Valsa mali differentially regulate pathogen virulence and response to abiotic stresses. J. Fungi 2021, 7, 830. [Google Scholar] [CrossRef]
- Bailey, B.A.; Bae, H.; Strem, M.D.; Antunez de Mayolo, G.; Guiltinan, M.J.; Verica, J.A.; Maximova, S.N.; Bowers, J.H. Developmental expression of stress response genes in Theobroma cacao leaves and their response to Nep1 treatment and a compatible infection by Phytophthora megakarya. Plant Physiol. Biochem. 2005, 43, 611–622. [Google Scholar] [CrossRef] [PubMed]
- Xiang, J.; Cheng, J.; Wei, L.; Li, M.; Wu, J. Functional analysis of the Nep1-like proteins from Plasmopara viticola. Plant Signal. Behav. 2022, 17, e2000791. [Google Scholar] [CrossRef] [PubMed]
- Cabral, A.; Oome, S.; Sander, N.; Kufner, I.; Nurnberger, T.; Van den Ackerveken, G. Nontoxic Nep1-like proteins of the downy mildew pathogen Hyaloperonospora arabidopsidis: Repression of necrosis-inducing activity by a surface-exposed region. Mol. Plant Microbe Interact. 2012, 25, 697–708. [Google Scholar] [CrossRef] [PubMed]
- Lian, J.; Han, H.; Chen, X.; Chen, Q.; Zhao, J.; Li, C. Stemphylium lycopersici Nep1-like Protein (NLP) is a key virulence factor in tomato gray leaf spot disease. J. Fungi 2022, 8, 518. [Google Scholar] [CrossRef] [PubMed]
- Westrick, N.M.; Ranjan, A.; Jain, S.; Grau, C.R.; Smith, D.L.; Kabbage, M. Gene regulation of Sclerotinia sclerotiorum during infection of Glycine max: On the road to pathogenesis. BMC Genom. 2019, 20, 157. [Google Scholar] [CrossRef] [PubMed]
- Rogers, C.W.; Challen, M.P.; Muthumeenakshi, S.; Sreenivasaprasad, S.; Whipps, J.M. Disruption of the Coniothyrium minitans PIF1 DNA helicase gene impairs growth and capacity for sclerotial mycoparasitism. Microbiology 2008, 154, 1628–1636. [Google Scholar] [CrossRef] [PubMed][Green Version]
- Yang, X.; Cui, H.; Cheng, J.; Xie, J.; Jiang, D.; Hsiang, T.; Fu, Y. A HOPS protein, CmVps39, is required for vacuolar morphology, autophagy, growth, conidiogenesis and mycoparasitic functions of Coniothyrium minitans. Environ. Microbiol. 2016, 18, 3785–3797. [Google Scholar] [CrossRef]
- Xu, Y.; Wu, M.; Zhang, J.; Li, G.; Yang, L. Cloning and molecular characterization of CmOxdc3 coding for oxalate decarboxylase in the mycoparasite Coniothyrium minitans. J. Fungi 2022, 8, 1304. [Google Scholar] [CrossRef] [PubMed]
- Yang, X.; Zhao, H.; Luo, C.; Du, L.; Cheng, J.; Xie, J.; Jiang, D.; Fu, Y. CmAim24 is essential for mitochondrial morphology, conidiogenesis and mycoparasitism in Coniothyrium minitans. Appl. Environ. Microbiol. 2020, 86, e02291-19. [Google Scholar] [CrossRef]
- Luo, C.; Zhao, H.; Yang, X.; Qiang, C.; Cheng, J.; Xie, J.; Chen, T.; Jiang, D.; Fu, Y. Functional analysis of the melanin-associated gene CmMR1 in Coniothyrium minitans. Front. Microbiol. 2018, 9, 2658. [Google Scholar] [CrossRef]
- Dodds, P.N.; Rathjen, J.P. Plant immunity: Towards an integrated view of plant-pathogen interactions. Nat. Rev. Genet. 2010, 11, 539–548. [Google Scholar] [CrossRef] [PubMed]
- Bernoux, M.; Ellis, J.G.; Dodds, P.N. New insights in plant immunity signaling activation. Curr. Opin. Plant Biol. 2011, 14, 512–518. [Google Scholar] [CrossRef]
- Campos, M.L.; Kang, J.-H.; Howe, G.A. Jasmonate-triggered plant immunity. J. Chem. Ecol. 2014, 40, 657–675. [Google Scholar] [CrossRef] [PubMed]
- Lenarčič, T.; Albert, I.; Böhm, H.; Hodnik, V.; Pirc, K.; Zavec, A.B.; Podobnik, M.; Pahovnik, D.; Žagar, E.; Pruitt, R.; et al. Eudicot plant-specific sphingolipids determine host selectivity of microbial NLP cytolysins. Science 2017, 358, 1431–1434. [Google Scholar] [CrossRef] [PubMed]
- Wang, S.-Y.; Zhang, Y.-J.; Chen, X.; Shi, X.-C.; Herrera-Balandrano, D.D.; Liu, F.-Q.; Laborda, P. Biocontrol methods for the management of Sclerotinia sclerotiorum in legumes: A Review. Phytopathology 2024, 114, 1447–1457. [Google Scholar] [CrossRef] [PubMed]
Disclaimer/Publisher’s Note: The statements, opinions and data contained in all publications are solely those of the individual author(s) and contributor(s) and not of MDPI and/or the editor(s). MDPI and/or the editor(s) disclaim responsibility for any injury to people or property resulting from any ideas, methods, instructions or products referred to in the content. |
© 2025 by the authors. Licensee MDPI, Basel, Switzerland. This article is an open access article distributed under the terms and conditions of the Creative Commons Attribution (CC BY) license (https://creativecommons.org/licenses/by/4.0/).